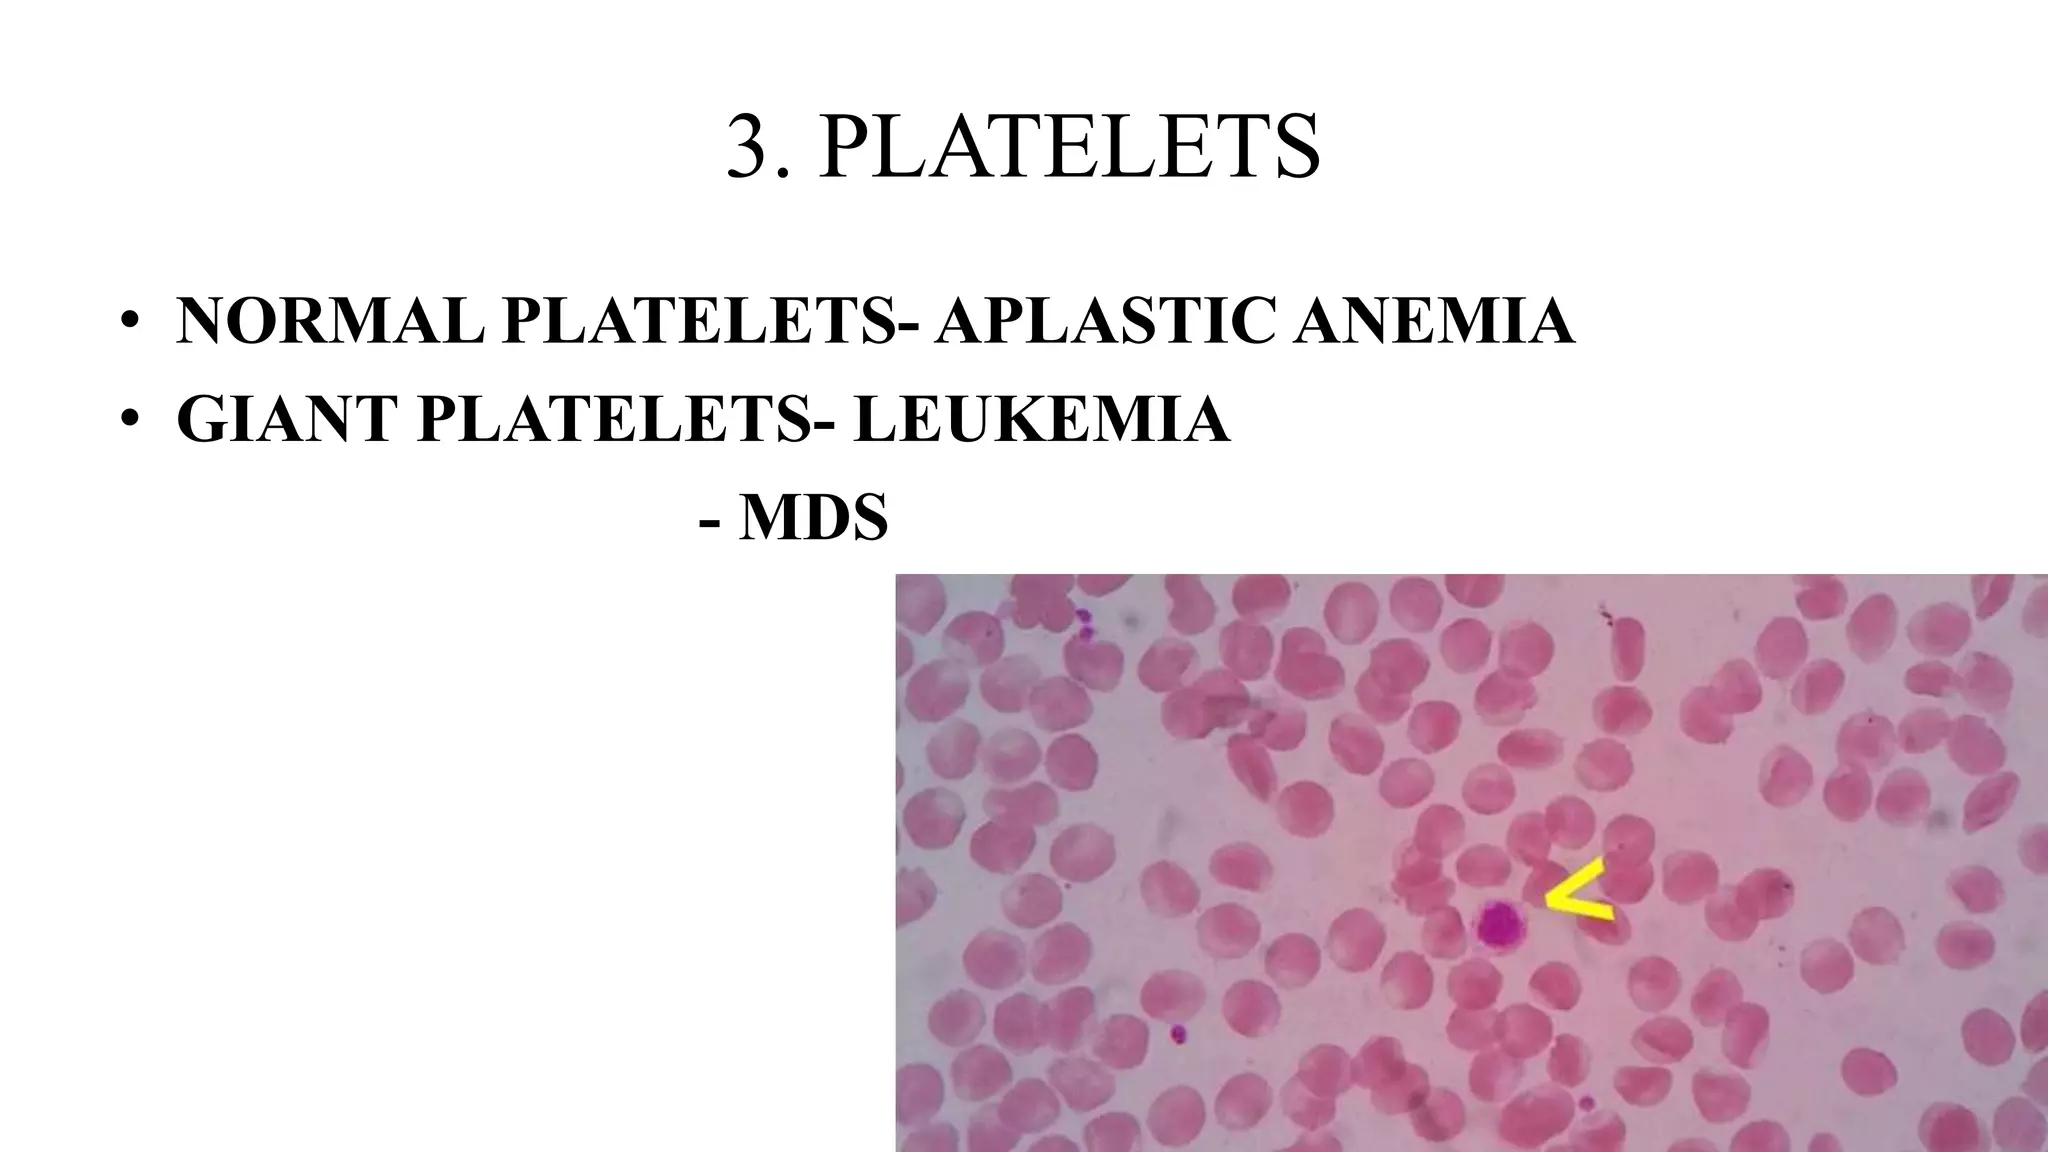
Laboratory investigations in pancytopenia PPTX Laboratory investigations in pancytopenia PPTX
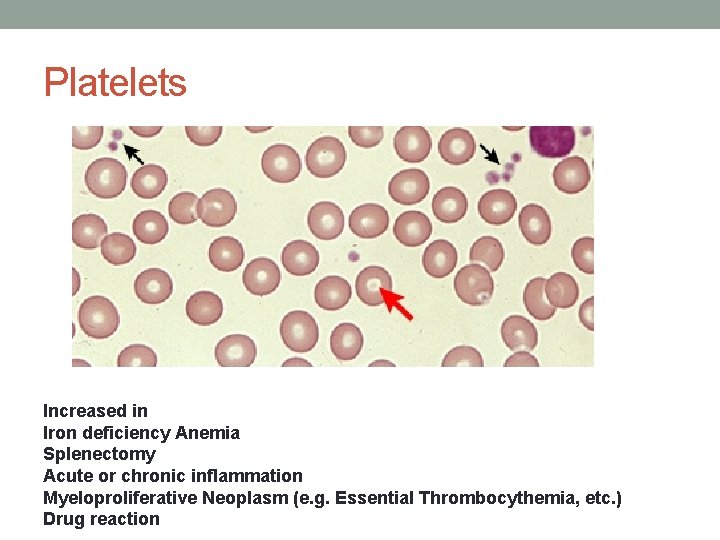
INTRODUCTION TO THE PERIPHERAL BLOOD SMEAR Rafi Ahmed INTRODUCTION TO THE PERIPHERAL BLOOD SMEAR Rafi Ahmed
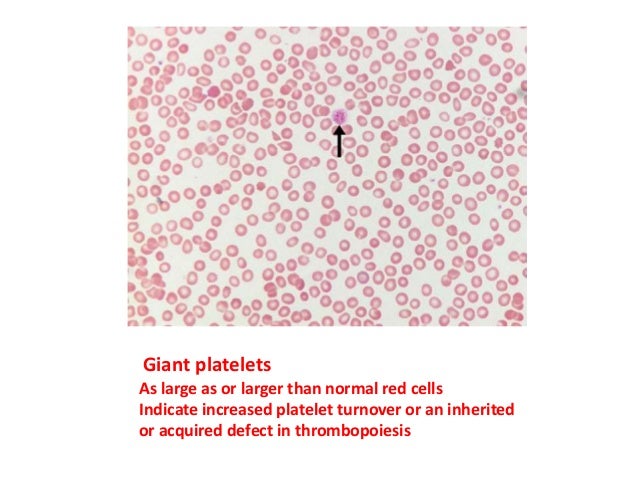
Blood film Blood film

8 Carol Court Baiting Hollow Ny
Here are some of the images for 8 Carol Court Baiting Hollow Ny that we found in our website database.

8

Bone marrow blood comp (8)
+are+about+150%2C+%2C000+cells/mm3+%2C+they+have+a+short+life+span+(5+to+9+days).jpg)
Chapter 19 The Blood ppt video online download

PPT Cardiovascular System PowerPoint Presentation free download ID

Circulatory System Honors Biology ppt video online download

PPT Leukopoeisis PowerPoint Presentation free download ID:2268381

PPT Blood Function PowerPoint Presentation ID:2960720

PPT MLAB 1227 Coagulation Keri Brophy Martinez PowerPoint

PPT Pediatric Hematology/Oncology Review Course Essential Concepts

Cardiovascular System: Blood ppt video online download

Histology of Blood tissue ppt download

PPT Peripheral Blood PowerPoint Presentation free download ID:1699779

Basics of Hematology cell counting agile affordable accurate

Normal Blood Cell Morphology Types of White Blood
.jpg)
Department of Anatomy Histology and Embryology Semmelweis University

PPT Burn injury and wound healing PowerPoint Presentation free

Components of blood and blood clotting mechanism PPTX

PPT Circulatory system PowerPoint Presentation free download ID

Circulation and Blood

Disease Disease is any condition that prevents the body working as it

Haemotology PPT

BIO 139 Lab Test #1 STUDY GUIDE ppt download

Platelets Thrombocytes Cell fragments bound to megakaryocytes
Laboratory investigations in pancytopenia PPTX

Abnormal Blood Cell Morphology Abnormal White Blood Cells

Hemolytic anemia akk PPT

PPT Chapter 17 Blood PowerPoint Presentation free download ID
INTRODUCTION TO THE PERIPHERAL BLOOD SMEAR Rafi Ahmed

PPT Chronic Myeloid Leukemia PowerPoint Presentation free download

Pin on Health

PPT BLOOD PowerPoint Presentation free download ID:2118343

PPT Humoral Immunity and Clotting PowerPoint Presentation free

PPT Chapters 10 11 Blood and Cardiovascular System PowerPoint

PPT EVALUATION OF THE BLEEDING PATIENT PowerPoint Presentation free
Blood film